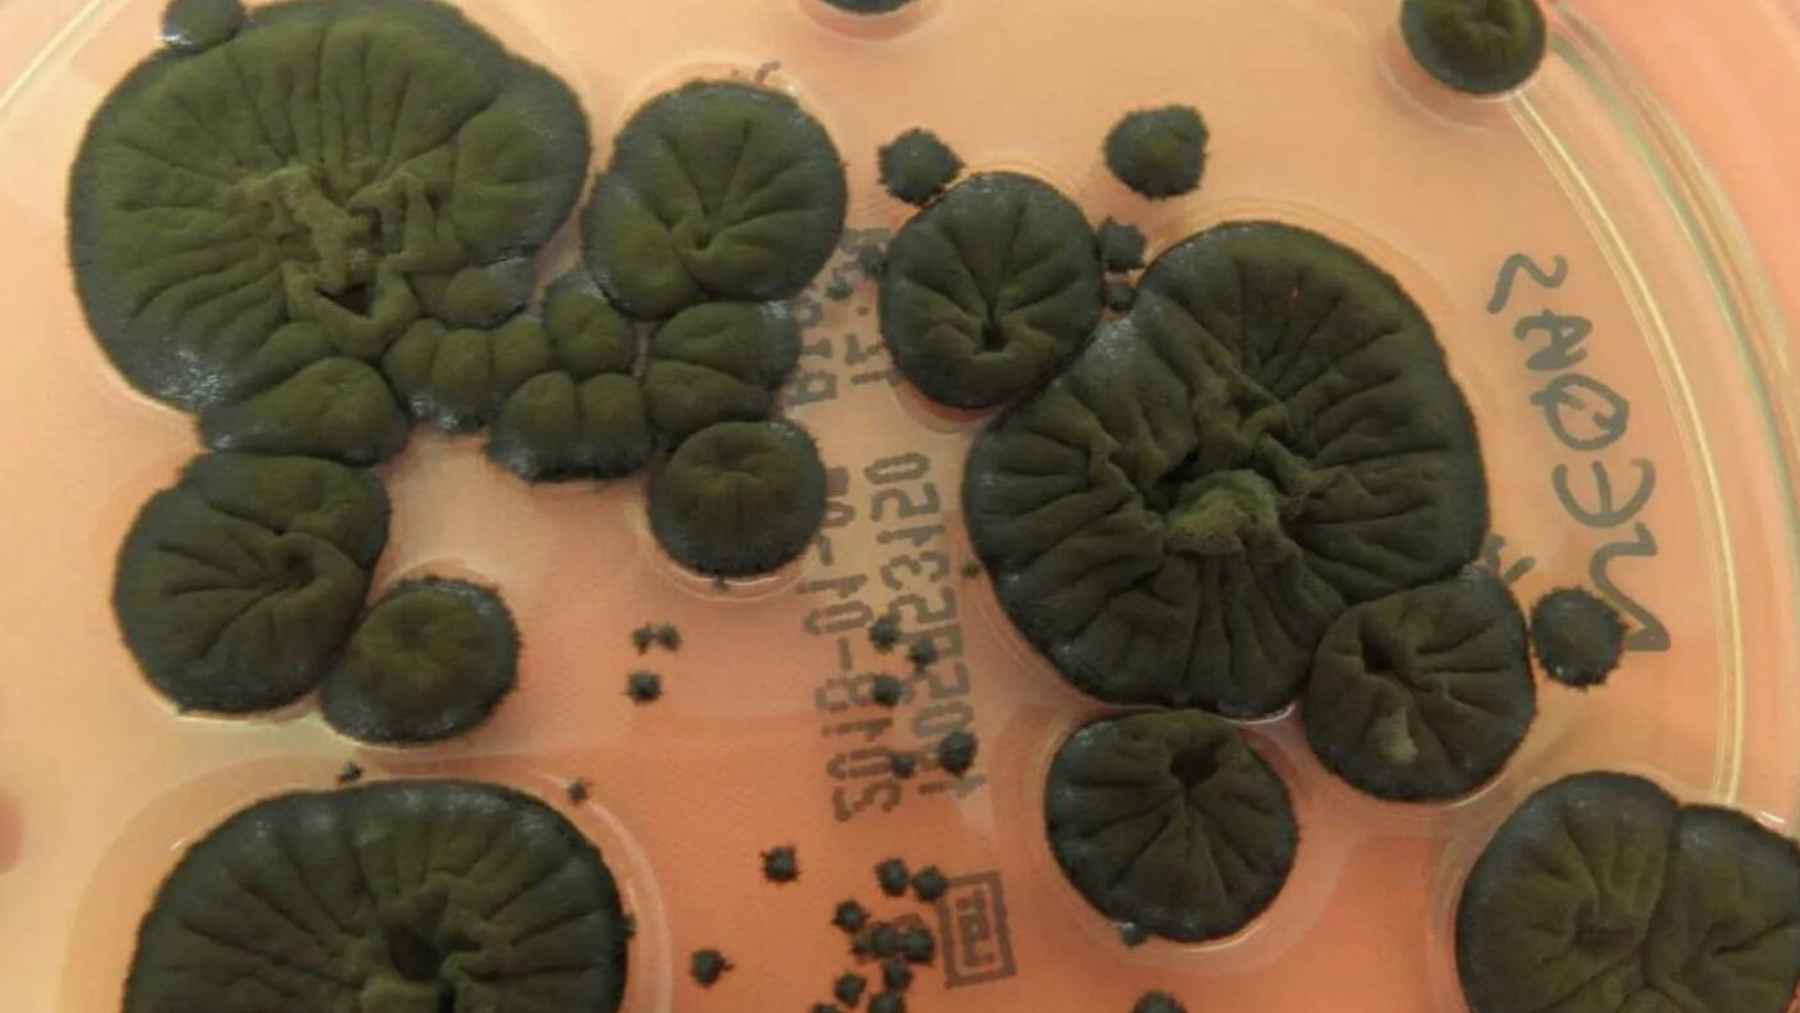
The incredible mutation of Chernobyl's black fungi that “feed” on radiation and that NASA wants to use to colonize Mars this year 1 Cladosporium sphaerospermum black fungus studied for its ability to survive high radiation and potential space applications.

What if one of the best tools for protecting astronauts did not come from a factory, but from Cladosporium sphaerospermum growing in one of the most radioactive places on Earth?
That is why scientists keep coming back to this dark fungus linked to Chernobyl that has shown an unusual ability to live with intense radiation.
The idea now is simple, but powerful. If this organism can grow where radiation is high, it might help build lightweight, self-repairing shields for future missions to the Moon and Mars, where space radiation remains one of NASA’s major human spaceflight hazards.
What scientists found at Chernobyl
The story starts inside the damaged reactor site at Chernobyl. Researchers reported extensive fungal growth on walls and structures inside the shelter in 1997 and 1998, with Cladosporium sphaerospermum among the commonly found species.
Another study later noted that, over about 15 years, scientists isolated roughly 2,000 strains from 200 species of fungi around the Chernobyl station. Some appeared to direct their growth toward radioactive sources. That alone was enough to raise eyebrows.
Why melanin keeps drawing attention
What makes this fungus so interesting? For the most part, the focus is on melanin, the dark pigment in its cell walls. A 2007 study found that ionizing radiation changed melanin’s electronic properties, and melanized fungi exposed to radiation roughly 500 times above background grew significantly faster than comparison cells.
The same paper also reported enhanced growth in melanized Cladosporium sphaerospermum under nutrient-limited conditions. Still, experts have not fully proven the popular idea that these fungi “feed” on radiation in the way plants use sunlight. “Radiosynthesis” is better understood as a serious hypothesis than a settled fact.
What the ISS experiment could mean for deep space travel
The most space relevant test came later on the International Space Station. In a 2022 experiment, researchers grew Cladosporium sphaerospermum in orbit and compared it with a ground control.
The fungus showed a 1.21 plus or minus 0.37 times higher growth rate in space. Sensors also recorded fewer radiation counts beneath the fungus side than beneath the no-growth control, which the authors said could point to partial shielding by the fungal biomass.
In practical terms, that matters because every extra layer of conventional shielding adds mass, and mass is a problem on any deep space mission. A living material that can be grown where astronauts land would change that equation.
So no, Chernobyl’s black fungus is not a finished space technology. Not yet. But it may be pointing engineers toward something they badly need, a shield that grows, repairs itself, and starts from biology instead of metal.
The study was published on Frontiers in Microbiology.












